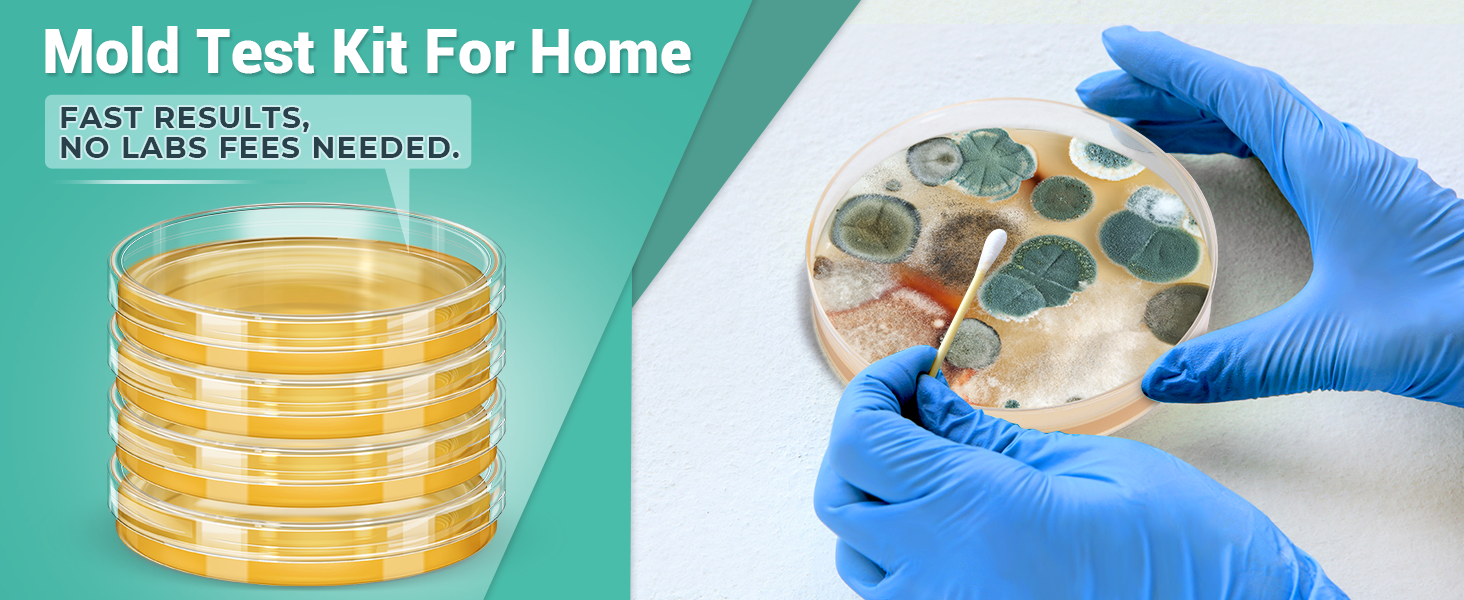
Mold Test Kit for Home

Mold Test Kit for Home Detection: 4 Simple DIY Science Kits for Fastly Testing Home Surfaces & Air Quality Detector & HVAC Monitor Includes Detailed Identification Guide
This comprehensive Mold Test Kit empowers you to quickly and accurately detect mold in your home. Featuring four easy-to-use DIY science kits, it allows fast testing of home surfaces, air quality detection, and HVAC monitoring. Detailed identification guides ensure you understand your results and take the right next steps for a safe environment.
Mold Test Kit for Home provides an all-in-one solution for detecting mold presence. Designed for easy use, this kit gives you confidence to test various areas within your home quickly and effectively. Keep your indoor environment safe with this user-friendly mold detection tool.

Comprehensive product details showcase the kit’s inclusions and features. From sampling tools to detailed instructions, everything you need is thoughtfully packaged. Learn about the materials and components that make testing reliable and precise.

The testing air quality detector helps monitor your home’s indoor air for mold spores and pollutants. Easily evaluate air health and ensure your living space remains clean and safe with this accurate air monitoring technology.

Achieve comprehensive testing coverage with easy-to-follow steps to assess multiple home areas. The kit is designed to support HVAC systems testing as well, helping you identify hidden mold sources and protect your family’s health effectively.

Benefit from free professional consultation included with the kit purchase. Expert guidance helps you interpret test results and plan remediation steps, ensuring you take the right measures for a mold-free, healthy home environment.

Conveniently test for mold presence from the comfort of your home with this all-inclusive kit. Its easy-to-use design makes mold testing accessible to everyone, helping protect your family’s well-being easily and efficiently every season.